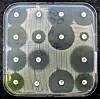
Antibiotika stoggar eller drep bakteriar i vekst (klår sone rundt lappar med aktivt legemiddel). Resistente bakteriar bryr seg ikkje og veks heilt inntil lappane med antibiotika.

Kunnskap
Resistent
Antibiotika stoggar eller drep bakteriar i vekst (klår sone rundt lappar med aktivt legemiddel). Resistente bakteriar bryr seg ikkje og veks heilt inntil lappane med antibiotika.
Foto: Wikimedia Commons
Det er ikkje lett å minnest kva det var vi var redde for før covid-19. Var det vanstyret under Donald Trump, høgrenasjonalismen i Ungarn eller det hemmelege brorskapet Illuminati? Mange såg nok på presidentpåfunn og ekstrem populisme som meir openberre trugsmål enn ein pandemi, no veit vi betre.
Men kva vil bli den største postpandemiske hovudverken? Av mange moglege plager kan legemiddelresistente bakteriar og sopp bli ein av dei verste.
Naturleg
Mikroorganismar har mykje til felles med makroorganismar som oss menneske. Til dømes bruker dei ei rekkje signalstoff til å kommunisere med omverda og for å finne ut kva dei skal gjere for å få maksimal vekst for seg og sine. Dei ligg òg støtt i krig med kvarandre om næring og om plass, her er det som regel snakk om kjemisk krigføring – og det er herfrå vi har henta dei stoffa vi no bruker som antibiotika.
På same vis som antibiotika er ein naturleg del av livet til mikroorganismane, er det difor også vanleg å finne gen for antibiotikaresistens.
Bakterieliv
Digital tilgang – heilt utan binding
Prøv ein månad for kr 49.
Deretter kr 199 per månad. Stopp når du vil.